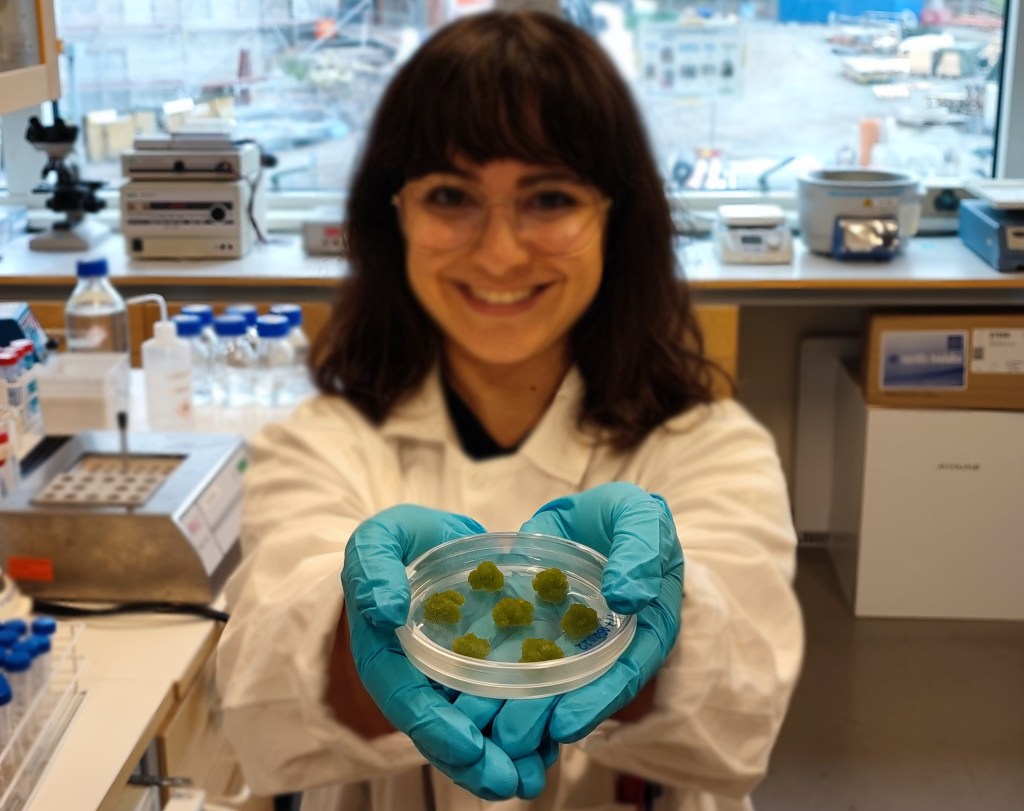

Here you can read about the different sources of funding that support our group’s research at KTH Glycoscience, including the goals and timelines of each funded project. The text below is largely taken directly from successful funding applications, and lays out our plans for each research project.
Finding peat alternatives for agriculture in Sweden’s most abundant industrial waste streams. Funded by Mistra. 2025-2028.

This project addresses two major environmental challenges for Sweden and the EU: the reduction of peat extraction and the accumulation of sludge waste at pulp and paper mills. The goal is to diminish the use of peat for casings in mushroom production and find alternatives for critical peat-dependent species like the common button mushroom, Agaricus bisporus. The extraction of peat from natural landscapes releases long-stored carbon, leading to major greenhouse gas emissions. As peat does not replenish quickly in nature, reduced availability may soon lead to scarcity in the media needed for mushroom growing. Peat alternatives are therefore vital for food security, as the demand for mushrooms, an increasingly popular low-calorie and vegan protein source, is projected to rise. The sludge produced in Sweden’s pulp and paper mills, currently a major environmental burden, offers potential as a substitute for peat in mushroom cultivation. Our proposal is to repurpose abundant sludge wastes from paper mills to promote sustainable, peat-free mushroom farming and contribute to Sweden’s circular bioeconomy. This funding was awarded to Dr Ulrike Schimpf of Stockholm University for a collaborative KTH-SU project.
New insights into enzyme stabilisation via attachment to non-catalytic accessory domains. Funded by Vetenskapsrådet, the Swedish research council for basic science. 2024-2027.

There is a pressing need to shift manufacturing industries towards truly sustainable processes. We must cease the use of fossil-derived polymers, and immediately find sustainable ways to use biomass instead. We need to re-focus industry on circularity, with zero-waste, low-impact thinking at its heart. A major source of pollution is the use of chemical catalysis in the production of specialist components, pharmaceuticals, platform chemicals, fuels, and materials. Switching to use enzymes can transform energy-intensive fossil-based production by facilitating the use of renewable raw materials, promoting design for recyclability, and reducing chemical consumption and waste. But biocatalysis has to be affordable and efficient to compete with standard practices. Taking inspiration from microbial approaches in nature, we will develop effective new ways to make enzymes stable and efficicent, to promote a green industrial revolution.
Uncovering new biocatalysts for waste remediation and valorisation in the pulp and paper sludge microbiome: A combined approach of strain isolation, DNA sequencing, and enzyme characterisation. Funded by the ÅForsk Foundation. 2023-2026.

We aim to create new methods for extracting valuable components from residues from the Swedish pulp and paper industry, to remediate polluting waste streams generated by the mills. Much of the sludge generated has a high organic content that could be useful for composting and in energy generation by burning or fermentation, but it is hard to recover due to a high water content in sludge. At the same time, the sludge contains metals that could be recycled if they could be recovered. We plan to characterise a series of different types of sludge waste to fully define what valuable components are present, in order to devise new strategies for remediation and resource recovery. This grant will support our sampling and characterisation activities, as well as microbial strain isolation and metagenome sequencing work to be performed as part of a WWSC-funded PhD project (see below).
Parallel approaches to minimise and remediate sludge wastes from the Swedish pulp and paper industry. Funded by the KTH Life Science platform. 2023-2024.

We are happy to receive an award from KTH to support networking and collaboration activities between departments working in the life sciences. In this project, we will collaborate with Prof. Minna Hakkarainen from the Division of Polymer Technology to explore parallel physical and chemical ways to break down, and recover resources from, the pulp sludge mentioned in the other projects described on this page. We will use these funds to purchase equipment, collect samples from industry, and begin preliminary tests to define our project goals. This will kick-start the WWSC-funded PhD project of Pakinee Thianheng, initiate a new collaboration between the McKee and Hakkarainen labs, and generate data for future larger funding applications.
Microbial community sequencing to profile the sludge breakdown process. Funded by the C.F. Lundström Foundation. 2023-2024.

This project aims to evaluate how enzymatic and microbial methods can be used to upgrade waste products from the pulp industry into fermentable sugars or recoverable metals. We plan to use enzymatic methods to break down the carbohydrates found in industrial sludge, releasing sugars that can be fermented for energy production. This will add value to the overall industrial production chain, while remediating a polluting waste stream. We we will use microbial isolation techniques and genomic DNA sequencing to identify dominant species, and use advanced “omics” methods to reveal the key enzymes active in sludge breakdown. We will then characterise these enzymes in detail to create new precision tools for the forestry biorefinery. The microbes and enzymes can be used to clean up the sludge waste piles by removing organic matter (leaving large amounts of recoverable metals), or to selectively modify and extract high molecular weight biopolymers. This grant will support sequencing work performed as part of a WWSC-funded PhD project (see below).
Defining the material properties and life cycle sustainability of a new class of chemical-free hydrogel biomaterials. Funded by the Carl Trygger Foundation. 2023-2025.

We have developed a new route to producing hydrogels from branched polysaccharides that avoids the chemical synthesis and fossil-based polymers used in current manufacture. Using newly discovered small proteins that bind to specific polymeric carbohydrates, we are able to produce viscous formulations and stable hydrogels in mild conditions by cross-linking polysaccharides. This innovative technology represents a sustainable route to biomaterials formation. It uses polymers that can be produced by fermenting fungi fed on waste biomass, promoting materials innovation and a transition to a circular production economy. After extensive preliminary discovery work, we are now ready to translate our observations into industry-ready innovation. While we have so far focussed on characterising the biochemistry underlying the cross-linking interaction, there is much to be done to understand the material properties of our gels.
Discovery and application of microbes and enzymes to recycle and add value to pulp and paper sludge. PhD project funded by the Wallenberg Wood Science Centre. 2023-2027.

Thousands of tonnes of sludge are produced each year at pulp and paper mills, and we aim to find new ways to recover components from this waste. The sludge contains lots of organic material such as cellulose, starch, degraded lignin, and microbial biomass. But it also contains metals and minerals that make the biomass hard to recycle and, since it cannot be burned for energy, it is sent to landfill. On-site observations suggest that there is a resilient microbial community in sludge piles. These microbes or their enzymes could be used to detoxify the waste, or be deployed in a biorefinery. In this project, co-supervised by Johan Larsbrink of Chalmers University, we will use isolation techniques and advanced “omics” methods to reveal the key enzymes in sludge breakdown.
Bridging the gap between fundamental research on lignin and industrial sustainability. Funded by the Anna and Nils Håkansson Foundation. 2022.
Moving towards a sustainable society, the need for alternative raw materials and reduction of industrial waste are of utmost importance. With long-term sustainable cultivation techniques in place, the forest can provide raw materials to replace many fossil-based analogues. Lignin, an abundant biopolymer, second only to cellulose and one of the three major wood components, is mainly used for the production of heat in pulp mills, where it is a by-product of the Kraft process. Lignin however exhibits many interesting properties in its non-degraded form, useful for high-value industrial applications, and so research on lignin has exponentially increased in the past decade. This project will help us to understand fundamental aspects of lignin in the wood, such as how its polymerization occurs, how it interacts with the other cell wall components, and finally its native structure, will enable fine-tuning of extraction protocols to obtain lignin unaltered and in high yields. This proposal was written by and awarded to Ioanna Sapouna.
Exploring the enzymatic modification of cellulose towards advanced functional materials. Funded by the ÅForsk Foundation. 2022-2024.

Cellulose is one of the most abundant and important natural resources and exists everywhere in nature. The development of green and sustainable products from cellulose, such as functional fibres and materials, is an extremely beneficial goal in a circular bioeconomy. One of the reasons why cellulose is so useful in materials development is because it can be modified to carry different chemical functional groups. This opens up a wide range of applications that can be made from sustainable cellulose. The work we are undertaking will generate significant new biological knowledge, and at the same time it will advance our research towards commercialisation of this new functional materials application. This proposal was written by and awarded to He Li, and will allow us to purchase advanced equipment to improve protein production and enzyme characterisation efforts in our lab.
Towards a lignin-first biorefinery: Deciphering the structure of native lignin. Funded by the C.F. Lundström Foundation. 2022.

Lignin is an abundant biopolymer, and important source of phenolic compounds such as vanillin, used in material science applications, for example in paints, asphalt, antimicrobial materials, and sunscreens. The variety of applications greatly depends on the structural properties of this complex biopolymer. PhD research by doctoral student Ioanna Sapouna focuses on native lignin. The unique structure of this polymer depends on many factors; from the plant species and age, to the extraction method used, a range of different lignin structures have been found in recent years. Understanding lignin production in the plant cell wall and optimising extraction methods that enable us to study the polymer in its native state is an important step towards building a true lignin-first biorefinery and promoting sustainability through multiple new applications. This proposal was written by and awarded to Ioanna Sapouna.
Fundamental aspects of native lignin polymerization, structure, and interactions. PhD project funded by the Wallenberg Wood Science Centre. 2019-2023.

We are grateful for ongoing salary support for Ioanna Sapouna from the Wallenberg Wood Science Centre, a Sweden-wide network with the theme of “Wood Nanotechnology – New Materials from Trees“. This funding enables research and education activities related to the biosynthesis, fractionation, and exploitation of wood components, aiming at biorefinery and biomaterial applications. The WWSC and associated Treesearch community offers networking opportunities, graduate schools, infrastructure access, and a direct line to experts in academia and industry in Sweden. This project in particular is looking for ways to extract lignin from wood without altering its structure too much, while developing methods to look more closely at that native structure. Ioanna uses a combination of chemical and biological methods to achieve this, and her results have implications for the design of a lignin-first biorefinery and native lignin-based material applications. These funds were awarded to lignin expert Prof Martin Lawoko, who devised the project.
Rheological characterisation of sustainable hydrogels exploiting a newly discovered protein:carbohydrate interaction. Funded by the Carl Trygger Foundation. 2022-2024.

We have developed a novel route to producing useful hydrogels from branched polysaccharides that avoids the chemical synthesis and fossil-based polymers used in current manufacture. We want to understand both the mechanism of gel formation and the physical properties of the material. In our molecular biology lab, we lack the resources necessary for a critical aspect of our work – we don’t have any reliable access to a rheometer, although rheological analysis of our hydrogels is absolutely vital for understanding the strength, properties, and potential applications of our materials. Thanks to this funding, we are now able to purchase an advanced rheometer for our lab!
A new sustainable route to polysaccharide hydrogel formation for medical and cosmetic applications. Funded by Formas, the Swedish research council for sustainability. 2020-2023.

Hydrogels are an extremely versatile class of material, and have found relevance in cosmetic, medical, pharmaceutical, and industrial processes. A hydrogel has a low solid content, often comprising at least 90% water. Although hydrogels are increasingly used, the production process is far from sustainable, relying on fossil-based polymers and chemical cross-linking steps, using compounds that are harmful to human health. We are investigating small proteins that can be used to cross-link polysaccharides (complex carbohydrate polymers), thereby creating a strong network that holds water, forming a hydrogel. The process avoids all chemical solvents, and allows us to use biopolymers of renewable natural origin, rather than synthetic or fossil-based polymers. We will soon test the biocompatability of our gels, so we can start designing some specific products for the cosmetic or biomedical sectors. This material will be commercialised by the spin-off Glycolink AB, founded 2021.
Engineering improved stability and substrate binding into enzymes for efficient hydrolysis of lignocellulosic biomass. Funded by the Swedish energy agency. 2020-2025.

The overall aim of this project is to enhance the efficiency of industrial biomass saccharification for biofuel production by designing and engineering new enzymes with enhanced hydrolytic capabilities and high thermostability. We are studying a new class of small protein domains found in some bacterial enzymes, and have demonstrated that they provide a truly significant boost to enzyme thermostability and hydrolytic capacity on complex biomass. We are exploring how wide-spread these domains are, and what kinds of enzyme activities they can boost, and are engineering stability into new target enzymes.
INTENT: INducible TransgENic Technology for disease resistance in plants. Funded by Vetenskapsrådet. 2017-2021.

The overall aim of INTENT was to improve crop plant defences against emerging infectious fungal diseases. This multi-disciplinary project combined biochemistry, molecular biology, and plant pathology. The project takes inspiration from naturally protective bacteria in the soil in order to design novel plant protection techniques, with relevance to food security, soil conservation, and climate change. This funding from Vetenskapsrådet provided Lauren with some stability and autonomy, so she could begin to establish a competitive new research team with the ambition to understand the roles of soil bacteria in biomass recycling and plant health, and to be inspired by these species to develop new technologies for sustainable agriculture and forestry, built on a strong foundation of molecular science.
Enzymatic epoxidation of suberin monomers for thermoset production. Funded by the Wallenberg Wood Science Centre. 2017-2019.

The epoxidation of suberin and cutin from tree bark to increase the content of epoxidised compounds would increase the yield of polymers available for the production of thermosetting bioplastics. This could valorise a waste-stream from the wood biorefinery, as bark is removed from the wood prior to processing. In this project, we worked with newly identified epoxidase enzymes from plants and microorganisms that can introduce epoxy groups to long chain fatty acids, in the hope of using them to epoxidise the monomers of suberin/cutin. We also optimised a mild biorefinery approach for the extraction of suberin from tree bark, which represents a sustainable high-value product. This work will be commercialised by the start-up company Reselo AB, founded 2021.
New approaches to the prevention of fungal disease in young trees inspired by beneficial soil bacteria. Funded by the Anna and Nils Håkansson Foundation. 2017.

Soil bacteria produce enzymes that attack the cell walls of pathogenic fungi. We discovered and characterised new anti-fungal enzymes with relevance for disease prevention in young trees. The use of natural enzymes from soil bacteria prevents the introduction of ‘foreign’ proteins to the forest ecosystem and reduces pesticide use. The project involved gene cloning, protein production, and enzyme characterisation.
